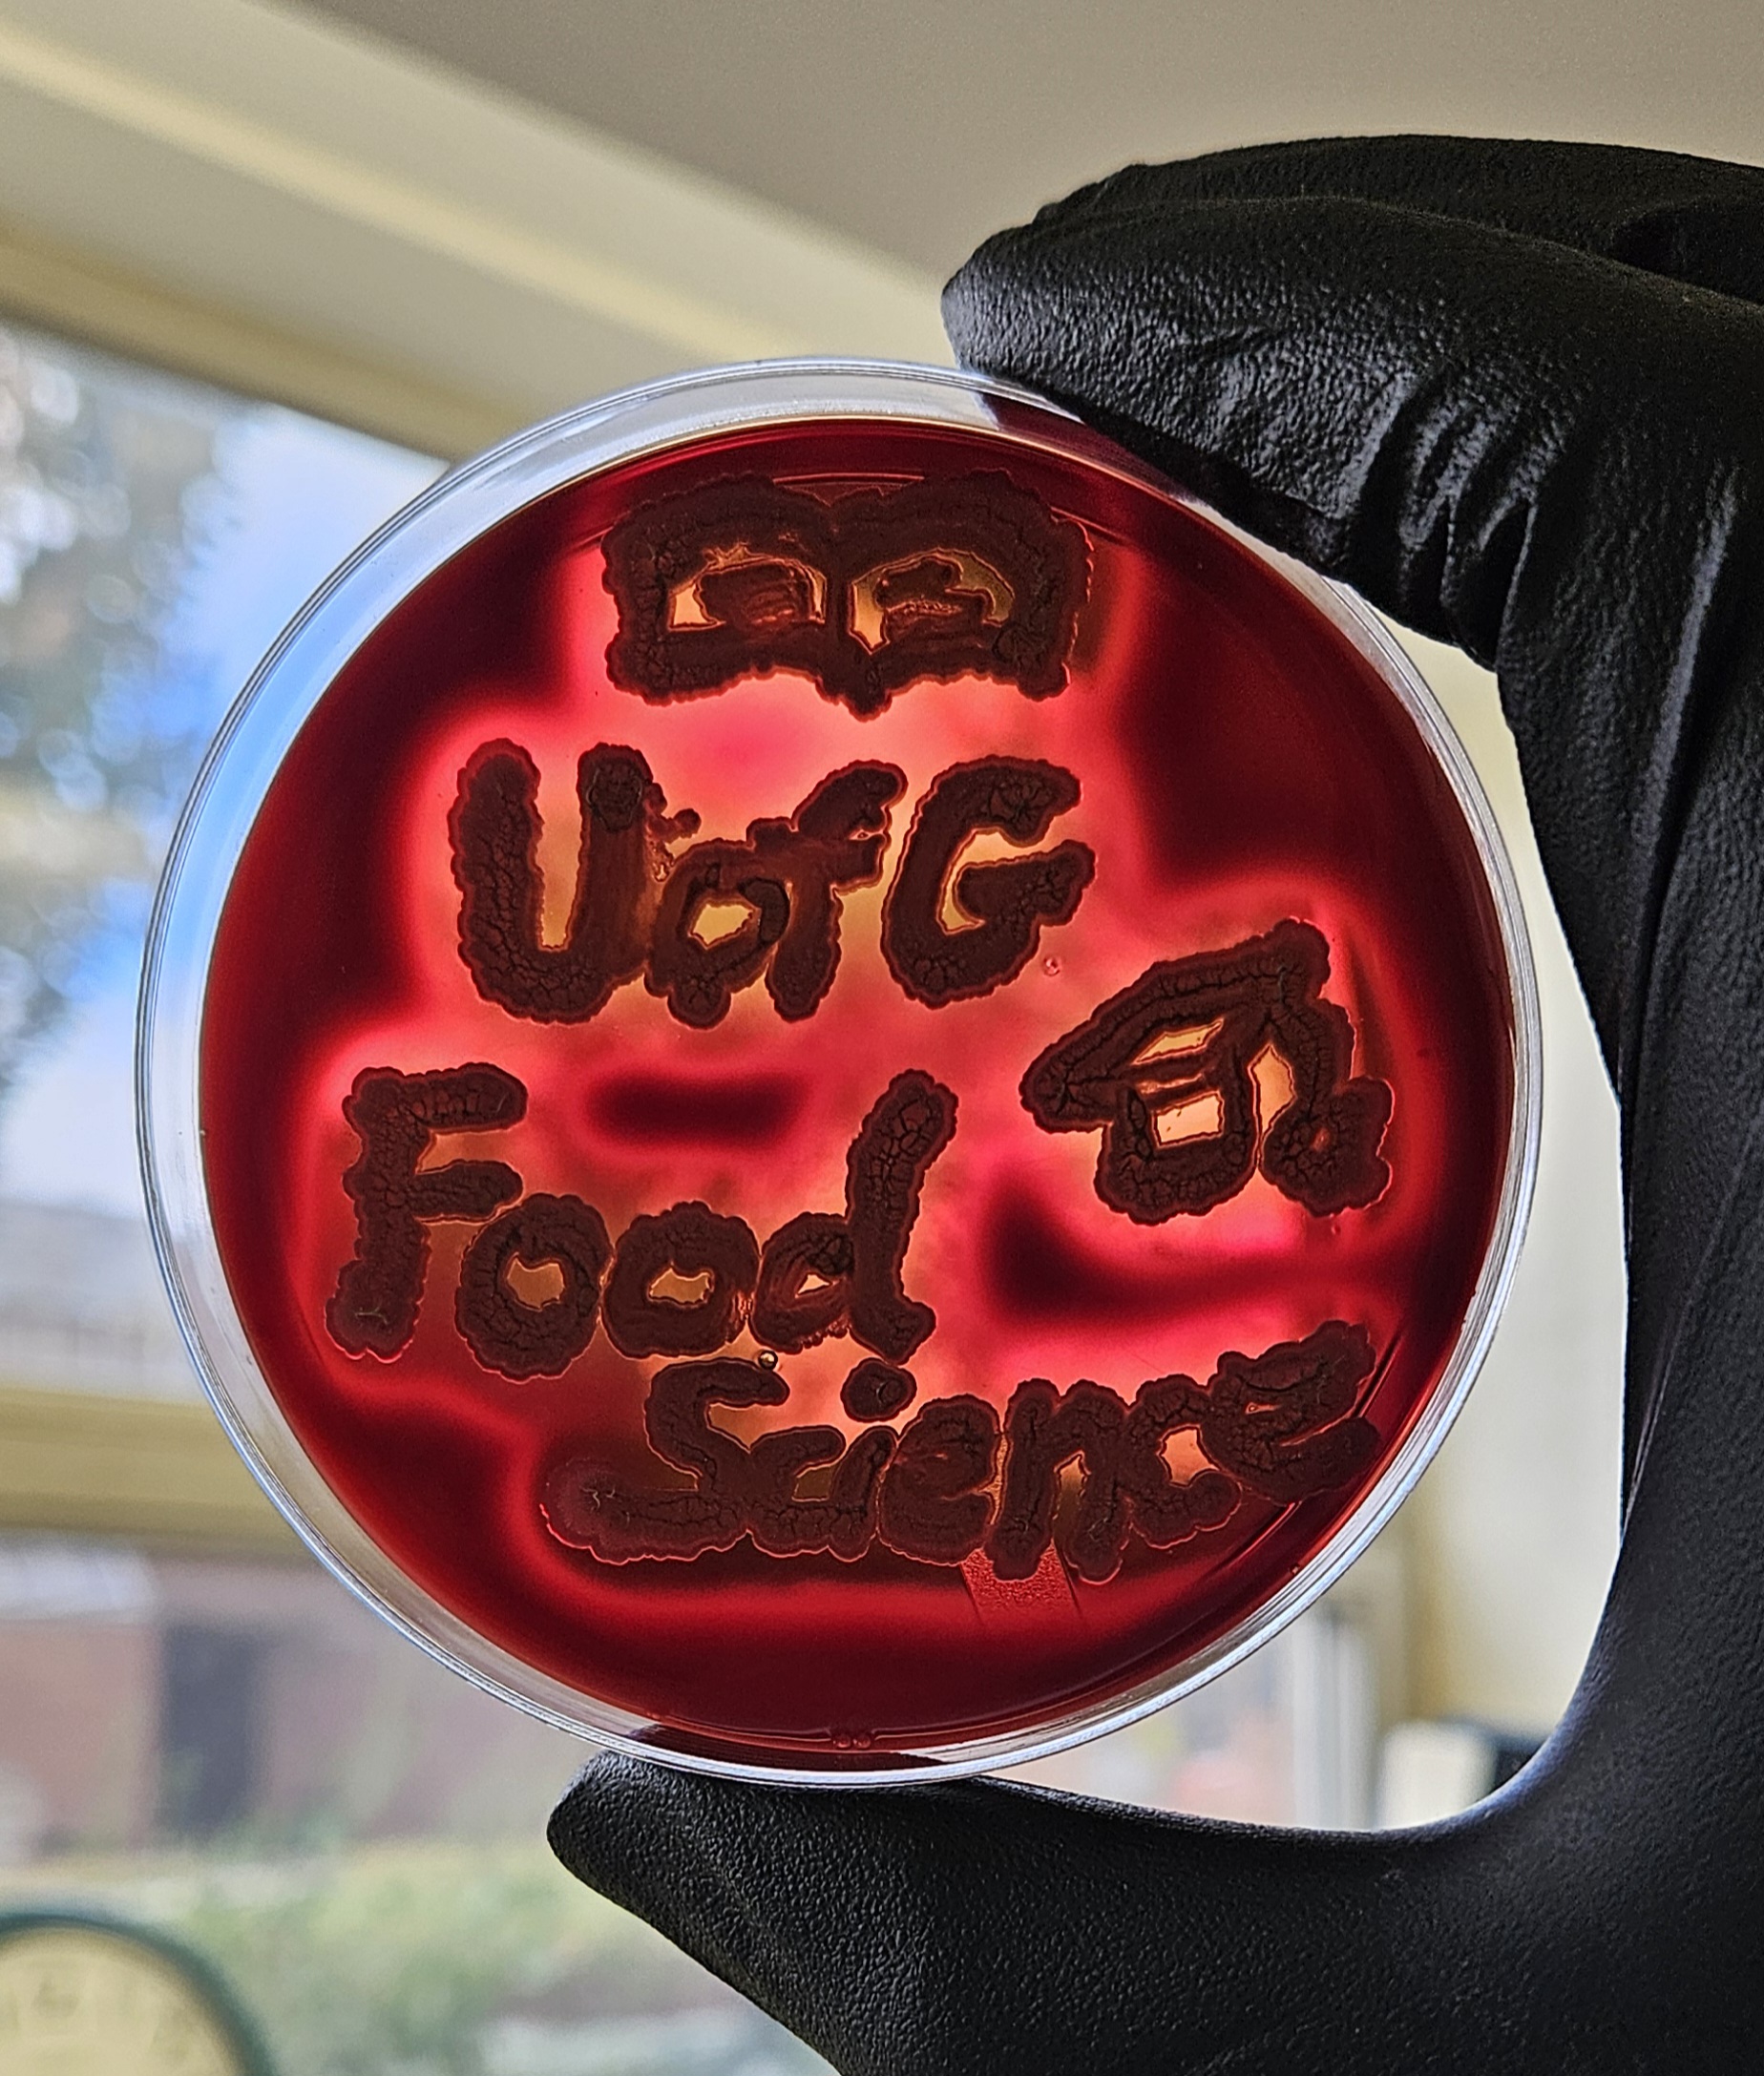

Here at the Food Science Department, interesting studies with a transdisciplinary vision toward Food Microbiology are happening to help consumers have a safe, healthy, and enjoyable experience of eating their favorite foods.
I am trying to find a natural way to control the transmission of harmful bacteria from farms to raw milk. In this picture, you can see one of the microbes I am working with which can lyse blood cells and form beautiful and clear halos on a Petri dish.